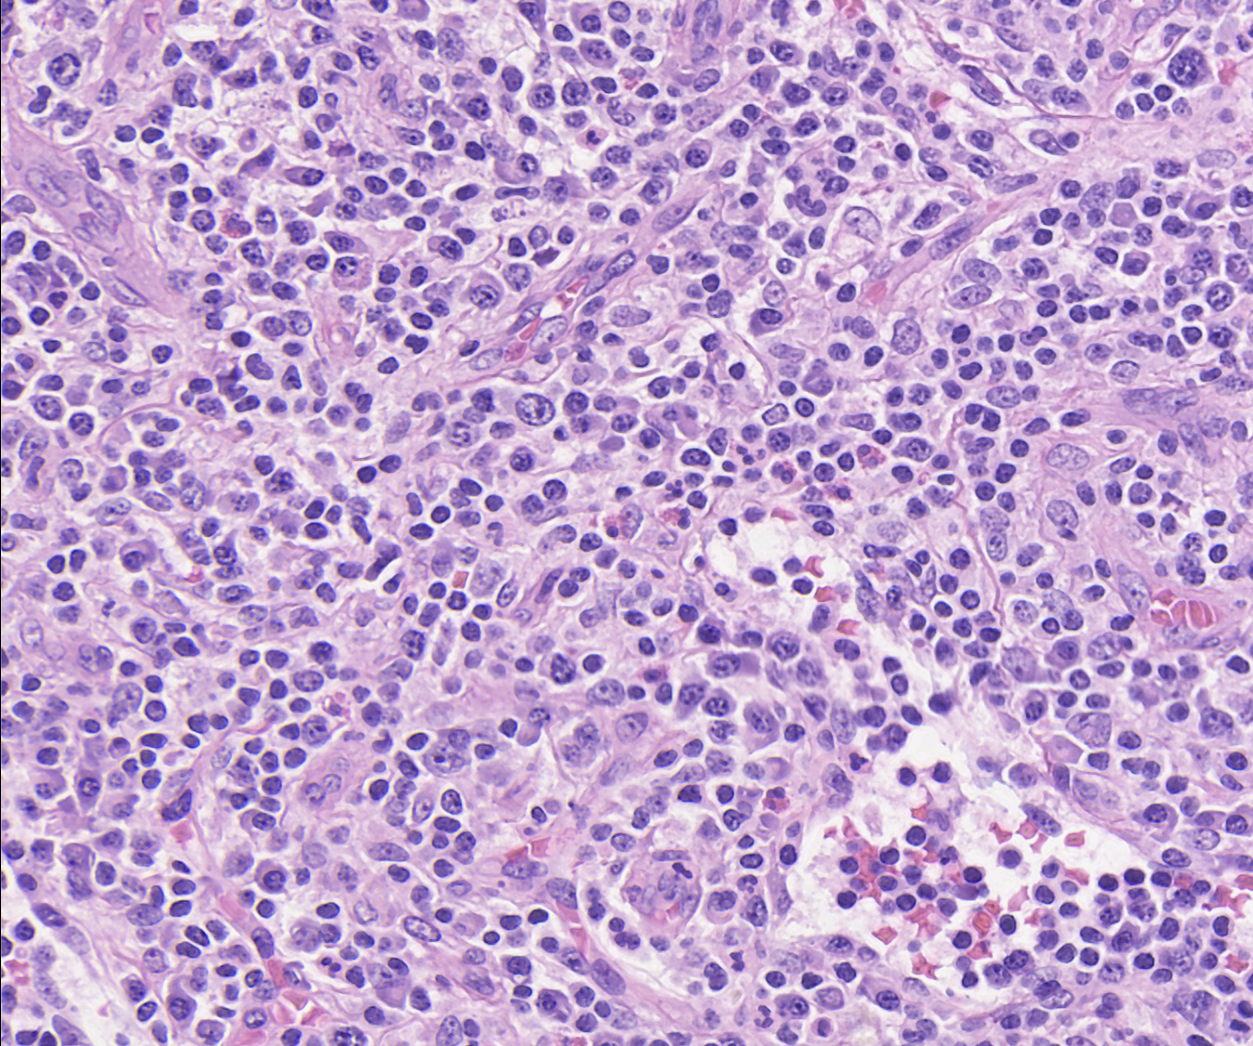

CLINICAL VIGNETTES
CASE 2
A 34-year-old woman reports progressive fatigue, swelling in her legs, and abdominal fullness over six weeks. Examination reveals ascites and peripheral edema. Laboratory evaluation shows hypoalbuminemia, elevated IL-6 levels, and polyclonal hypergammaglobulinemia. Imaging reveals enlarged abdominal lymph nodes and effusions.
Misdiagnosis
The patient was initially diagnosed with systemic lupus erythematosus (SLE) and treated with corticosteroids for nearly a year. While symptoms partially improved, they recurred after steroid tapering.
Learn about grading follicular atresia and view examples.
Grading Insight
The biopsy was graded as Grade 2 plasmacytosis, Grade 3 follicular atresia, and Grade 1 vascularity, consistent with Castleman disease.
Treatment